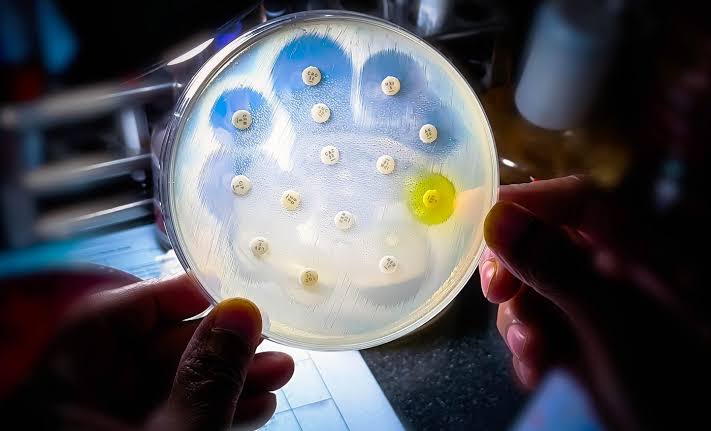
WHO warning: High percentage of common infections worldwide are no longer responsive to antibiotics

Antimicrobial resistance to common bacteria is rising worldwide, eroding the effectiveness of last-l...
WHO warning: High percentage of common infections worldwide are no longer responsive to antibiotics
Antimicrobial resistance to common bacteria is rising worldwide, eroding the effectiveness of last-line antibiotics against bacteria.
Author: Earth.com
Read Original Article








































